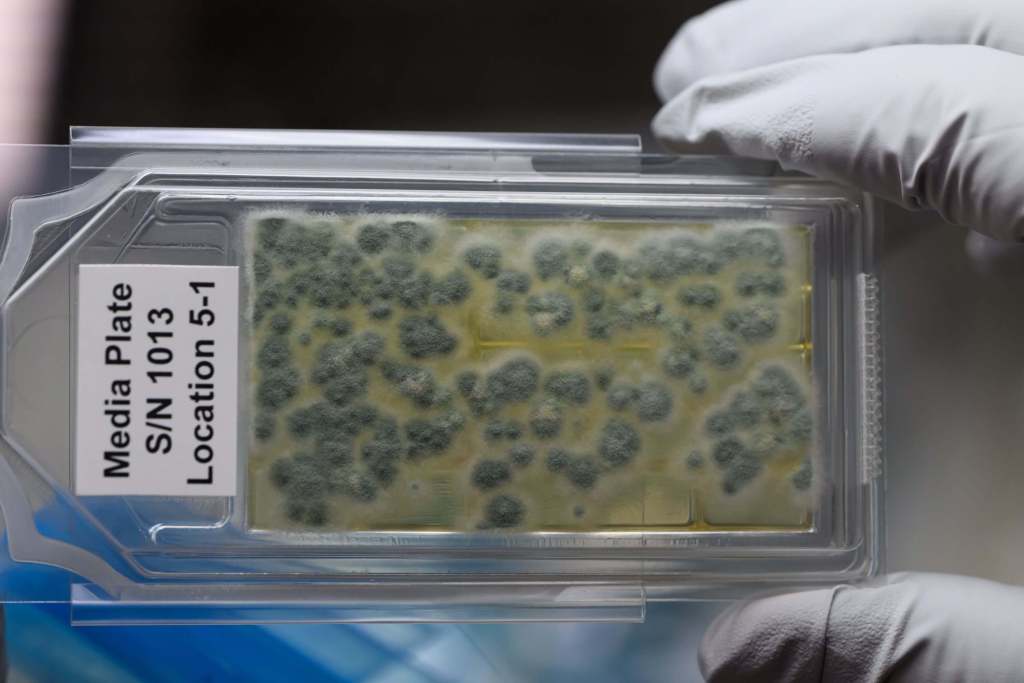

La Estación Espacial Internacional (EEI) ha sido, a lo largo de 2024, un hervidero de investigaciones científicas que abarcan desde experimentos biológicos hasta avances tecnológicos de vanguardia. Estas actividades amplían nuestro entendimiento del espacio y generan innovaciones con aplicaciones directas en la Tierra.
La NASA ha publicado recientemente un álbum fotográfico que destaca los momentos más significativos de estas investigaciones en la EEI durante este año. Las imágenes capturan la dedicación de los astronautas y científicos que, en un entorno de microgravedad, llevan a cabo estudios cruciales para el futuro de la exploración espacial y el bienestar humano. Viaja por este fantástico álbum con nosotros.
1. La astronauta Loral O’Hara lleva a cabo un estudio sobre células óseas dentro del Life Science Glovebox
12 de febrero de 2024
La astronauta de la NASA, Loral O’Hara, trabaja en MABL-A, una investigación que analiza cómo la microgravedad afecta a las células responsables de la formación ósea y la reparación del tejido esquelético. Los resultados podrían ayudar a los científicos a comprender los mecanismos moleculares básicos de la pérdida ósea que ocurre durante los vuelos espaciales y también debido al envejecimiento en la Tierra.

2. La astronauta Jasmin Moghbeli posa frente al Hábitat Avanzado para Plantas
18 de enero de 2024
La astronauta de la NASA, Jasmin Moghbeli, sonríe junto al Hábitat Avanzado para Plantas, donde crecen varios cultivos de tomate como parte del experimento Plant Habitat-06. Este estudio analiza cómo los vuelos espaciales afectan el sistema inmunológico de las plantas y su producción, con el objetivo de mejorar el cultivo y la producción de alimentos en futuras misiones espaciales.

3. Suni Williams trabaja en el proyecto StemCellEX-H1
2 de octubre de 2024
La astronauta de la NASA, Suni Williams, participa en el desarrollo de StemCellEX-H1, una tecnología diseñada para la producción de células madre humanas en el espacio. Estas células se utilizan como terapias para tratar ciertas enfermedades de la sangre y tipos de cáncer. En un entorno de microgravedad, podría ser posible producir estas células en mayores cantidades y con una calidad superior a la que se logra actualmente en la Tierra.

4. Fotografía de larga exposición mientras la Estación Espacial Internacional sobrevolaba el lago Míchigan a 257 millas de altitud
24 de octubre de 2024
Mientras la estación espacial pasaba a unas 250 millas sobre el lago Míchigan, el astronauta de la NASA Don Pettit tomó esta impresionante fotografía de larga exposición. En la imagen, se pueden ver las luces de las ciudades trazando líneas a través de la superficie de la Tierra, mientras una aurora verde y roja atraviesa la atmósfera. Observar el alumbrado urbano desde el espacio permite a los investigadores obtener información sobre la densidad poblacional, la expansión de las ciudades y la prevención de desastres.

5. La astronauta Tracy C. Dyson trabaja en la investigación Gaucho Lung
20 de mayo de 2024
La astronauta de la NASA, Tracy C. Dyson, participa en el proyecto Gaucho Lung, un estudio que analiza cómo se administran medicamentos en el sistema respiratorio en condiciones de microgravedad, donde es posible aislar las fuerzas que influyen en el comportamiento de los líquidos. Los resultados podrían descubrir nuevas formas de administrar medicamentos y contribuir al desarrollo de recubrimientos antiadherentes para tuberías de líquidos, útiles en el sector de la salud, la industria alimentaria y otras aplicaciones.

6. La astronauta Suni Williams instala el equipo del experimento Packed Bed Reactor.
15 de agosto de 2024
La astronauta de la NASA, Suni Williams, trabaja en la instalación del equipo para el experimento Packed Bed Reactor. Este tipo de reactor utiliza un tubo lleno de cuentas porosas que maximizan el contacto entre un líquido y un gas que fluyen a través de él. Estos reactores tienen múltiples aplicaciones, como en sistemas de soporte vital para la recuperación de agua y la gestión térmica, además de su uso en celdas de combustible tanto en el espacio como en la Tierra.

7. La astronauta Jeanette Epps procesa muestras de sangre y saliva
1 de agosto de 2024
La astronauta de la NASA, Jeanette Epps, guarda muestras de sangre y saliva del experimento Immunity Assay en un congelador científico para su análisis futuro. Este experimento tiene como objetivo desarrollar un test funcional en pleno vuelo que permita monitorear cómo los factores de estrés en los viajes espaciales afectan las funciones del sistema inmunológico.

8. La astronauta Loral O’Hara posa frente al Microgravity Science Glovebox
8 de marzo de 2024
La investigación Flawless Space Fibers-1 logró fabricar más de siete millas de fibra óptica en un solo mes, demostrando por primera vez que es posible producir longitudes comerciales de fibra en el espacio. En esta imagen, la astronauta de la NASA Loral O’Hara se prepara para trabajar con el equipo del experimento. La fibra óptica fabricada en microgravedad es de mayor calidad que la producida en la Tierra y tiene numerosas aplicaciones en medicina, defensa, ciberseguridad y telecomunicaciones, tanto en nuestro planeta como en el espacio.

9. Placa de muestra del experimento GEARS
24 de abril de 2024
Esta placa contiene bacterias recolectadas en la Estación Espacial Internacional. El experimento GEARS utiliza análisis genéticos para identificar cepas que podrían haber desarrollado resistencia a los antibióticos, representando un posible riesgo para la salud de los miembros de la tripulación. Este conocimiento podría ayudar a los científicos a diseñar estrategias para proteger a los astronautas en futuras misiones de larga duración.
10. Llama sobre combustible sólido en el experimento SoFIE-GEL
21 de marzo de 2024
Una llama se curva alrededor de una esfera de combustible sólido como parte del experimento SoFIE-GEL, que analiza cómo la temperatura del combustible influye en la inflamabilidad de un material. Este estudio busca mejorar la comprensión del comportamiento del fuego y ayudar a definir las técnicas más efectivas para su extinción, contribuyendo a mejorar la seguridad contra incendios en futuras instalaciones espaciales.

11. Despliegue de CubeSats desde la Estación Espacial
29 de agosto de 2024
Los CubeSats, diseñados para grupos educativos, gubernamentales y privados, impulsan el avance de la ciencia y la tecnología en diversas disciplinas. Los pequeños satélites listos para su lanzamiento son CosmoGirl-Sat, SaganSat0, SAKURA, Wiseseed Sat y Binar-2/3/4. Estos dispositivos compactos representan una herramienta clave para la investigación espacial y el desarrollo tecnológico en múltiples áreas.

12. El Dr. Dmitry Oleynikov teleopera un robot quirúrgico en la Estación Espacial
10 de febrero de 2024
Desde una consola en Lincoln, Nebraska, el Dr. Dmitry Oleynikov controla de forma remota un robot quirúrgico a bordo de la Estación Espacial Internacional, como parte de la demostración tecnológica Robotic Surgery Tech Demo. Este experimento prueba técnicas para realizar procedimientos quirúrgicos simulados a distancia. Los resultados podrían impulsar el desarrollo de sistemas robóticos que permitan realizar cirugías en casi cualquier lugar y momento.





